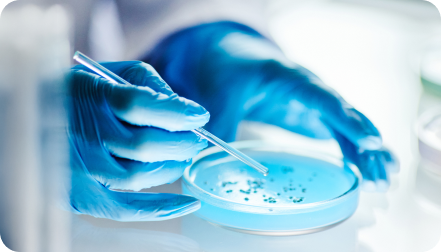

Solicita hora con equipo médico especialistas UC CHRISTUS
Modelo de atención multidisciplinario.
Atención
en Centro Médico Lira 85.
Laboratorio e imágenes de
última generación.
Atención médica
humanizada
y centrada en el paciente
La nueva Unidad de Micobacterias UC CHRISTUS surge con el propósito de brindar una atención integral, centrada en el paciente y sustentada en la mejor evidencia científica, a personas con sospecha o diagnóstico de enfermedades causadas por micobacterias, incluyendo tuberculosis y micobacteriosis no tuberculosas.
Comprenden principalmente la tuberculosis y las infecciones producidas por micobacterias no tuberculosas.

La enfermedad pulmonar por micobacterias, que es la forma más frecuente de presentación, corresponde a una enfermedad lenta, crónica y que persiste a pesar del tratamiento habitual de una neumonía .
Sintomas:
Ante la sospecha de una enfermedad por micobacterias o la presencia de una enfermedad confirmada, puedes consultar en la Unidad de Micobacterias UC CHRISTUS.
Somos un equipo de profesionales de UC CHRISTUS, dedicados al diagnóstico y seguimiento de pacientes con enfermedades por micobacterias.
Brindamos una atención personalizada y de excelencia, basada en la colaboración entre distintas especialidades. Cada caso es analizado en instancias multidisciplinarias, lo que permite definir estrategias de manejo integrales y ofrecer controles y evaluaciones ambulatorias ajustadas a las necesidades específicas de cada paciente.
Brindamos atención a pacientes con previsión Fonasa o Isapres.
Principales especialidades
A continuación ingresa los datos del paciente: